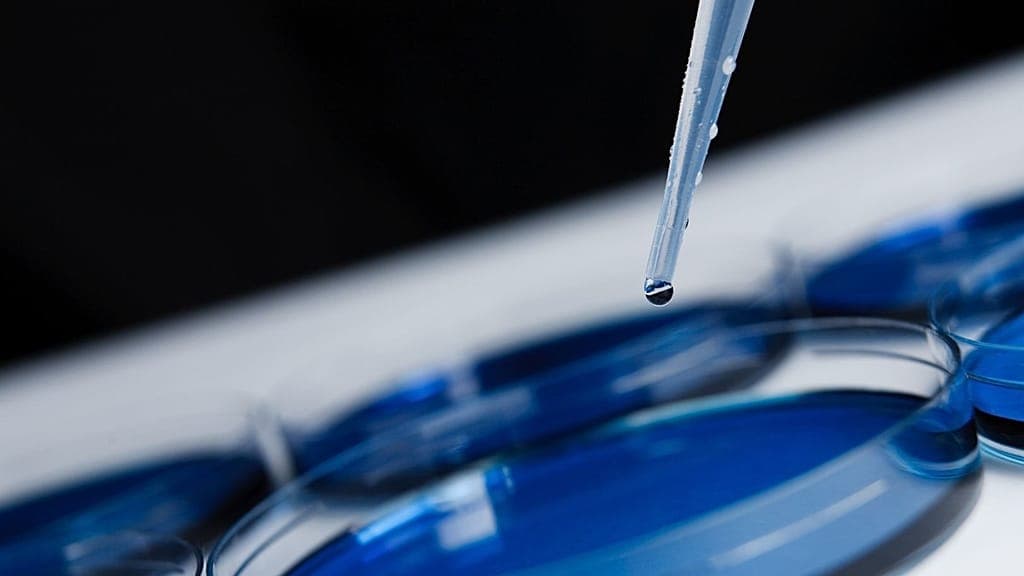

The US administration announced new federal funding to harness artificial intelligence for accelerating pediatric oncology research. The initiative commits $50 million to a data effort doubling previous support, aiming to analyze medical records, advance diagnostics, expedite trials and boost prevention amid broader science funding cuts.
Điểm nổi bật:
- The US administration commits an extra $50 million to AI-driven pediatric cancer research.
- NIH’s Child Cancer Data Initiative funding doubles to $100 million despite broader science budget cuts.
- AI will analyze medical records to improve diagnosis, speed clinical trials, and bolster prevention efforts.
- Pediatric oncology research routinely receives under 10% of federal cancer funds, and recent cuts threaten progress.
Động thái tăng gấp đôi tài trợ trong bối cảnh cắt giảm ngân sách khoa học
Tổng thống Donald Trump đã công bố một sắc lệnh hành pháp mới nhằm sử dụng trí tuệ nhân tạo (AI) để tăng tiến bộ trong cuộc chiến chống lại ung thư trẻ em.

Sắc lệnh cam kết tài trợ mới 50 triệu đô la (43 triệu euro) cho một sáng kiến dữ liệu ung thư ở trẻ em, lần đầu tiên được đưa ra trong nhiệm kỳ đầu tiên của Trump. Các quan chức cho biết khoản tài trợ này sẽ giúp thu thập và phân tích một lượng lớn dữ liệu y tế, sử dụng AI để cải thiện chẩn đoán, tăng tốc thử nghiệm lâm sàng và tăng cường các nỗ lực phòng ngừa.
"Chúng tôi sẽ kết nối trí tuệ nhân tạo với tất cả những thứ khác mà chúng tôi có trong tay", ông Trump nói tại Phòng Bầu dục hôm thứ Ba. "Và chúng tôi sẽ tìm câu trả lời và những đứa trẻ này thực sự, một số hoàn toàn tốt hơn và những đứa khác đang trở nên tốt hơn".
Ung thư trẻ em: hiếm gặp nhưng tàn phá
Mặc dù tương đối hiếm, ung thư là nguyên nhân hàng đầu gây tử vong liên quan đến bệnh tật sau khi còn nhỏ ở trẻ em ở Hoa Kỳ. Hiệp hội Ung thư Hoa Kỳ ước tính rằng khoảng 9.550 trẻ em ở Hoa Kỳ sẽ được chẩn đoán mắc bệnh ung thư vào năm 2025.
Trong khi tỷ lệ sống sót đã được cải thiện đáng kể - với tỷ lệ tử vong do ung thư ở trẻ em giảm hơn 50% kể từ năm 1975 - tỷ lệ mắc bệnh đã tăng đều đặn kể từ những năm 1970.
Trên toàn cầu, ung thư ảnh hưởng đến khoảng 400.000 trẻ em và thanh thiếu niên dưới 19 tuổi mỗi năm, theo Tổ chức Y tế Thế giới (WHO).
Nghiên cứu ung thư nhi khoa cũng vẫn thiếu kinh phí kinh niên, chiếm chưa đến 10% ngân sách nghiên cứu ung thư liên bang, theo Tổ chức Ung thư Trẻ em.
Sắc lệnh hành pháp tăng gấp đôi cam kết của Viện Y tế Quốc gia đối với Sáng kiến Dữ liệu Ung thư Trẻ em, nâng tổng số tiền tài trợ lên 100 triệu đô la. Nhưng nó diễn ra trong bối cảnh cắt giảm tài trợ khoa học liên bang.
Trong những năm gần đây, hàng trăm nhà khoa học đã bị loại khỏi bảng lương liên bang và hàng trăm triệu đô la tài trợ - bao gồm một số nghiên cứu ung thư trẻ em hỗ trợ - đã bị hủy bỏ.
Hiệp hội Khối u Não Nhi khoa, một mạng lưới quốc gia đã cho phép trẻ em tiếp cận với các phương pháp điều trị thử nghiệm trong hơn 25 năm, đã được thông báo vào tháng 8 rằng họ sẽ không còn nhận được hỗ trợ liên bang nữa. Các dự thảo ngân sách trước đó cũng đề xuất cắt giảm hơn một phần ba tài trợ của Viện Ung thư Quốc gia, nhưng những cắt giảm đó vẫn đang được đàm phán.
Mạng lưới Hành động Ung thư của Hiệp hội Ung thư Hoa Kỳ cảnh báo rằng việc cắt giảm được đề xuất sẽ khiến quốc gia này lùi lại đáng kể khả năng giảm tử vong và đau khổ.
Viễn cảnh ứng dụng tại Việt Nam
Xét về bối cảnh Việt Nam, việc ứng dụng trí tuệ nhân tạo (AI) trong nghiên cứu ung thư trẻ em mang lại nhiều cơ hội và thách thức. Trước hết, các trung tâm y tế lớn như Bệnh viện Nhi Trung ương và Viện Huyết học Truyền máu Trung ương có thể tận dụng dữ liệu bệnh án điện tử để xây dựng mô hình chẩn đoán sớm và cá nhân hóa phác đồ điều trị. Đồng thời, cần đầu tư cơ sở hạ tầng điện toán đám mây và huấn luyện nguồn nhân lực để vận hành hệ thống AI.
Ngoài ra, việc kết hợp dữ liệu từ các quỹ nghiên cứu, tổ chức phi chính phủ và bệnh viện công tư có thể tạo ra mạng lưới chia sẻ thông tin rộng lớn, giúp củng cố cơ sở dữ liệu ung thư trẻ em quốc gia. Tuy nhiên, quy định bảo mật dữ liệu y tế ở Việt Nam cần được hoàn thiện để bảo vệ quyền riêng tư và tránh rủi ro lộ lọt thông tin cá nhân. Việc hợp tác quốc tế trong chuyển giao công nghệ và đào tạo chuyên gia cũng sẽ là nhân tố quyết định giúp AI nhanh chóng đóng góp vào công tác phòng chống ung thư trẻ em tại Việt Nam.